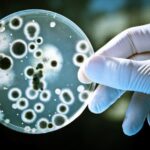
ideonella sakaiensis

Una sfida fuori dai banchi

Il ragno
Il mio gioco preferito era quello del “ragno”: consisteva nell’attraversare un piccolo sentiero pieno di fili. Lo scopo del gioco era di non toccare nessuno di questi fili, se non ci riuscivi e lo toccavi per più di due volte avevi perso.
La prima volta che l’ho percorso ho perso subito, ma poi facendolo ancora avevo scoperto la strategia, per cui l’ho svolto con più facilità. Alla fine del gioco ero tutta sporca di terra, sembravo proprio una talpa. Ma la tattica consisteva proprio in questo, ovvero strisciare per terra. Me ne sono accorta dopo perché all’inizio non avevo proprio intenzione di sdraiarmi, ma osservando alcuni compagni che avevano trovato questa strategia, ci ho provato anche io e dopo tutti gli altri. Infatti siamo riusciti tutti ad attraversare il percorso. Grazie a questo gioco ho imparato che certe volte, al posto di fare di testa mia, posso osservare gli altri e prendere esempio. Sono emerse le personalità diverse dei miei compagni, le qualità più belle, che delle volte teniamo nascoste dietro una maschera che ci impedisce di essere noi stessi e di dimostrare agli altri chi siamo e come siamo veramente.
Margherita Mosca
Le bocce
Uno dei giochi che più mi ha entusiasmato è stato quello delle bocce. Per riuscire a completarlo ho impiegato molti tentativi, ma alla fine ce l’ho fatta. Il gioco consisteva nel lanciare la boccia il più vicino possibile al boccino, una piccola pallina che viene lanciata all’inizio del gioco.
Penso sia un gioco molto competitivo e molto divertente, ma anche imprevedibile quando pensi di vincere all’ultimo tiro uno dei tuoi avversari ti sposta la boccia così da vincere lui la partita. Anche se ci ho messo molto tempo per completarlo ho imparato una cosa: non bisogna mai darsi per vinti ma bisogna continuare a dare il massimo. Mi sono anche divertito a sfidare i miei compagni e mettere alla prova le mie abilità nel cercare di strappare al campione in carica la vittoria così da proseguire il percorso di giochi nel Luna Park della collinetta del Parco Lambro.
Niccolò Bisi
Il bowling
Uno dei giochi che ha tirato fuori da me una certa grinta, è quello del bowling. Consisteva nel far cadere dei bicchieri, col rispettivo punteggio, utilizzando solo 3 palline, cercando di totalizzare almeno 100 punti. Detto così sembra un gioco semplicissimo, ma la difficoltà era che i bicchieri con il punteggio minore erano più vicini al punto da dove si lanciava, invece quelli con un punteggio maggiore erano più lontani, quindi più difficili da buttare a terra.
Questa sfida ci ha fatto pensare che in questi tre anni potremo diventare una classe molto unita perché quando era il turno di un compagno quelli in fila aspettando il loro momento, facevano il tifo per l’altro, incoraggiandolo e sostenendolo. Questo mi ha ricordato la frase che ci ha detto il preside Grava “se il nostro compagno è triste lo siamo anche noi e se lui è felice anche noi lo diventiamo”, infatti è proprio vero che siamo legati ai nostri compagni e che questo c’entra con il clima della classe.
Amelie Barreca
Il gioco delle carte consisteva nell’indovinare quella che il giudice pescava e si doveva indovinare se la carta successiva fosse maggiore o minore rispetto a quella che aveva appena pescato e così via. Questo gioco non sempre andava di fortuna perché spesso dovevi ragionare sul valore della carta e pensare a quale potesse essere la successiva.
Mi sentivo emozionata al mio turno e avevo un’adrenalina positiva: questo permetteva di riprovare fino a quando non indovinavo. All’inizio pensavo fosse solo un gioco di casualità ma poi mi sono accorta che si poteva ragionare. Per me questa è stata la cosa più bella, fare un gioco e usare la testa e i numeri!
Giulia Bernaus
Ognuno di noi ha sfruttato questa occasione per rivelare ai nostri compagni la nostra vera personalità che spesso è nascosta dietro una maschera. Ci siamo accorti di possedere delle nuove qualità mettendoci in gioco, buttandoci nelle diverse sfide “fuori dai banchi”, ma forse anche in classe, nelle ore di lezione, può valere la stessa scoperta.